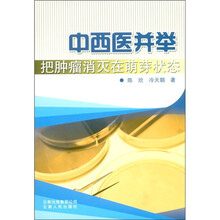
中西医并举把肿瘤消灭在萌芽状态（附光盘1张）

中西医并举把肿瘤消灭在萌芽状态(附光盘1张)
作者:陈欣 著
出版:云南人民出版社 2011.4
页数:234
定价:30.00 元
ISBN-13:9787222072565
ISBN-10:722207256X
去豆瓣看看 第一章 风雨飘摇 中华医术日趋衰落
中医衰落的现实状况
中医衰落的几大缘由
中医衰落的历史渊源
路漫漫其修远兮,何以求索(上)
路漫漫其修远兮,何以求索(中)
路漫漫其修远兮,何以求索(下)
中医大师吴佩衡诞辰120周年祭(上)
中医大师吴佩衡诞辰120周年祭(下)
第二章 异军突起 中草药诊治癌症崭露头角
中西医并举,把癌症消除在萌芽阶段
癌症病因及其发展规律初探(上)
癌症病因及其发展规律初探(下)
药物污染更致癌
肿瘤预防之我见
早期恶性肿瘤的中草药药理诊断
恶性肿瘤能否治愈
癌症病因探析及与防治专家商榷
癌症高发:抗生素滥用的恶果
肿瘤合并烧热症防治的思路与方法
浅谈肿瘤合并臌胀症防治失误的教训
肿块形态变化不能一概视为病情恶化
漫谈癌症防治中疼痛状况的种种缘由
淋巴结肿大与肿瘤指标物飙升的误诊
浅谈疑难病症施治中的四点辩证关系
西医诊断结果在中医临床治疗中的应用
漫谈肿瘤防治中的“王道”与“霸道”
免疫功能衰弱与紊乱之间的本质差异初探
变一种方法防治肿瘤
肿瘤患者康复后病灶不一定消失
癌症患者自我检测的三个标准
癌症临床防治反应规律
免疫疗法治疗癌症的机理和辅助疗法的选择初探
“阴阳平调”系列药物在癌症防治中的作用
肿瘤病人择医时易犯的错误
癌症患者面对的两种选择
云南草药治疗癌症临床反应规律及注意事项
第三章 实事求是 实验报告证奇效
云南中草药“阴阳平调”系列药物实验报告
中医纠正免疫功能紊乱辅以扶阳温化法在癌症诊治中的
两大作用
关于加强医疗机构中药制剂管理的意见
扶持促进医疗机构中药制剂发展
后记
陈欣(冷崇怀):1952年生于云南宣威,学医长达35年,多年来,撰写了20余篇理论文章,其对肿瘤早期的预防以及治疗得到了中医界泰斗王雪苔、邓铁涛、朱良春、吕嘉戈、李今庸等人的肯定,被肿瘤患者誉为“肿瘤克星”。曾出版过《挑战死神,云南中草药治疗癌症专辑》一书。冷天朝:师承父亲陈欣,毕业于云南中医学院。在其父免疫功能紊乱理论的基础上对免疫系统功能病变和中医外治有深入研究。擅长运用“阴阳平调系列方药”配合独创的外治法治疗各种癌症和疑难病,具有丰富的癌症治疗临床经验。
癌症在现今已成为人类的第一杀手,人们谈癌色变。由于早期癌症在人体内不易被发现,一旦经过仪器诊断就已经是中晚期。故征服癌症首先在于早期发现,而今对此似乎无法做到。有时中医早期诊断出癌症,病人仍然要去西医院进行确诊,但多数情况下通过仪器和血液检查却无法查出,病人对中医的疑惑是存在的,而中医大夫能对癌症早期诊断者也是凤毛麟角,这样就使病人失去了最佳的治疗时机。
《中西医并举把肿瘤消灭在萌牙状态》的作者陈欣大夫对攻克癌症已取得了阶段性的成功,现在需要做的事情就是继续深入研究癌症的形态和成因,根据中医一物降一物的自然界法则,真正找到降癌的药物,将癌症这个影响人类生命的顽症彻底攻克,这才是最艰难的事情。
《中西医并举把肿瘤消灭在萌牙状态》讲述了作者在癌症治疗中的心得体会。
比价列表
缺书网
缺书网 扫码进群
扫码进群




